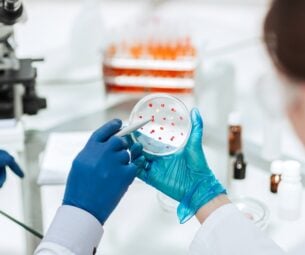

Why choose us
Our focus is on your overall well-being and helping you achieve science research.
our steps
Expert’s
Process

Meet Team
United for Science
and Innovation


Emily Sanders

James Thornton

Laura Bennett

Samuel Brooks

Carlos Martinez
3 m +
managed
27 +
projects launched
98 %
satisfaction rate
50 k +
driven through SEO
Choose the ideal plan
Our Testimonial
“ Working with this team completely changed my financial outlook. From retirement planning to investment strategies, they provided clear guidance and tailored solutions that made me feel secure about my future. ”
“ Working with this team completely changed my financial outlook. From retirement planning to investment strategies, they provided clear guidance and tailored solutions that made me feel secure about my future. ”
“ Working with this team completely changed my financial outlook. From retirement planning to investment strategies, they provided clear guidance and tailored solutions that made me feel secure about my future. ”
“ Working with this team completely changed my financial outlook. From retirement planning to investment strategies, they provided clear guidance and tailored solutions that made me feel secure about my future. ”